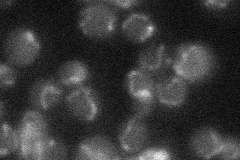
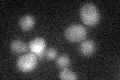

View description
Non-essential mitochondrial protein of unknown function; mRNA induced during meiosis, peaking between mid to late prophase of meiosis I; similar to S. douglasii YSD83
Localization:
Intensity:
Fold change:
Significance:
-
C’ GFP library in SD

below threshold15.27 -
N' NOP1pr-GFP in SD

mitochondria48.9132 -
N' TEF2pr-mCherry in SD

mitochondria43.3417 -
N' NATIVEpr-GFP in SD
punctate,mitochondria21.3649 -
N' TEF2pr-VC and Cyto-VN in SD

below threshold23.784 -
C’ GFP library in SD+DTT

cytosol16.531.08No -
C’ GFP library in SD+H2O2

cytosol19.541.27No -
C’ GFP library in Starvation Media
cytosol30.141.97No -
C’ GFP library on the background of Pup2-DaMP

below threshold -
C’ GFP library on the background of CCT mutant

below threshold16.47271.07864No
